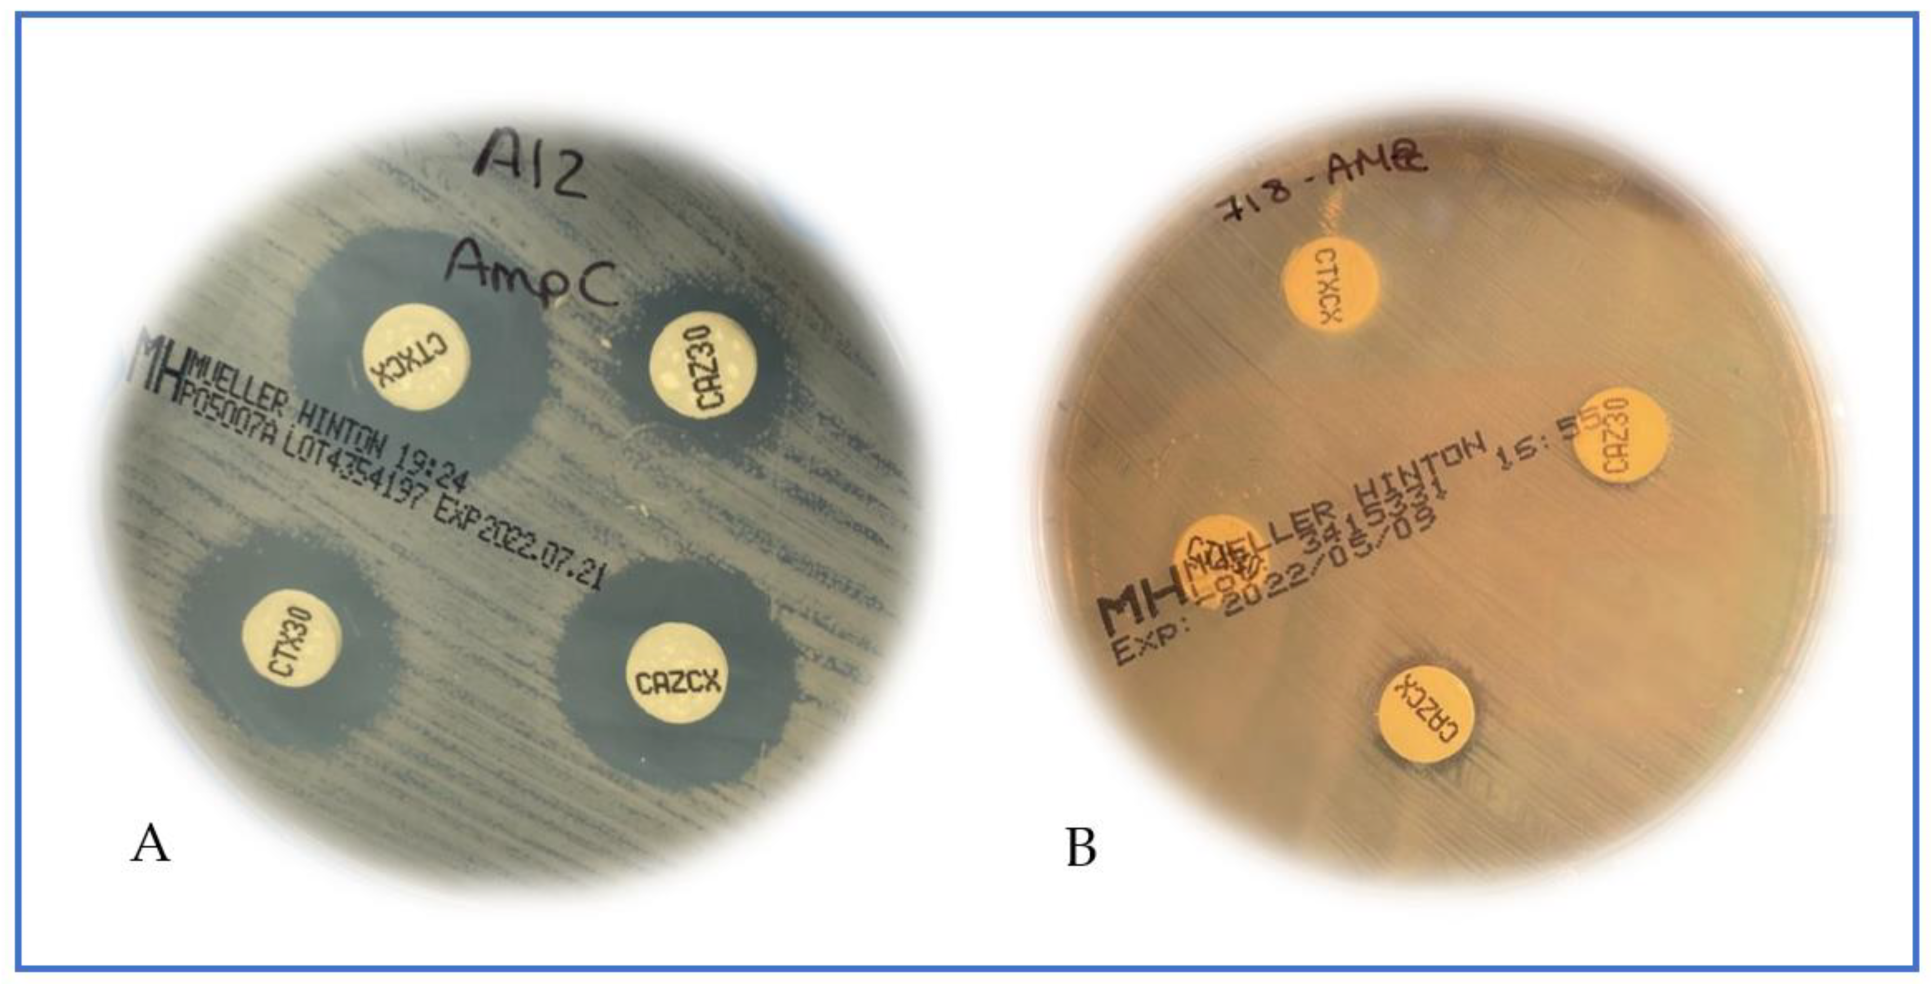
Antibiotics 11 01130 g001

Rapid Detection of Plasmid AmpC Beta-Lactamases by a Flow Cytometry Assay
Abstract
:1. Introduction
2. Results
3. Discussion
4. Materials and Methods
4.1. Detection of pAmpC β-Lactamases
4.2. Detection of Other β-Lactamases
4.3. Statistical Analysis
5. Conclusion
6. Patents
- 1.
- Kit and method for detecting the resistant microorganisms to a therapeutic agent. WO/2012/164547 A1. Granted in Europe (Application granted 6 December 2012).
- 2.
- Fluorescent method for detecting microorganisms resistant to a therapeutic agent. US14123757. Granted in USA (Application granted 22 March 2016).
Author Contributions
Funding
Institutional Review Board Statement
Informed Consent Statement
Data Availability Statement
Acknowledgments
Conflicts of Interest
References
- Murray, C.J.; Ikuta, K.S.; Sharara, F.; Swetschinski, L.; Aguilar, G.R.; Gray, A.; Han, C.; Bisignano, C.; Rao, P.; Wool, E.; et al. Global burden of bacterial antimicrobial resistance in 2019: A systematic analysis. Lancet 2022, 399, 629–655. [Google Scholar] [CrossRef]
- Tamma, P.D.; Aitken, S.L.; Bonomo, R.A.; Mathers, A.J.; van Duin, D.; Clancy, C.J. Infectious Diseases Society of America Guidance on the treatment of AmpC β-lactamase-producing Enterobacterales, carbapenem-resistant Acinetobacter baumannii, and Stenotrophomonas maltophilia infections. Clin. Infect. Dis. 2022, 74, 2089–2114. [Google Scholar] [CrossRef] [PubMed]
- Mizrahi, A.; Delerue, T.; Morel, H.; Le Monnier, A.; Carbonnelle, E.; Pilmis, B.; Zahar, J.R.; Saint-Joseph/Avicenna Study Group. Infections caused by naturally AmpC-producing Enterobacteriaceae: Can we use third-generation cephalosporins? A narrative review. Int. J. Antimicrob. Agents 2020, 55, 105834. [Google Scholar] [CrossRef] [PubMed]
- Martínez-Martínez, L. Carbapenemases: The never-ending story. Enferm. Infecc. Microbiol. Clin. 2019, 37, 73–75. [Google Scholar] [CrossRef]
- Ambler, R.P. The structure of beta-lactamases. Philos. Trans. R. Soc. Lond. Ser. B Biol. Sci. 1980, 289, 321–331. [Google Scholar]
- Bush, K.; Jacoby, G.A. Updated functional classification of beta-lactamases. Antimicrob. Agents Chemother. 2010, 54, 969–976. [Google Scholar] [CrossRef]
- Jacoby, G.A. AmpC beta-lactamases. Clin. Microbiol. Rev. 2009, 22, 161–182. [Google Scholar] [CrossRef]
- Seral, C.; Gude, M.J.; Castillo, F.J. Emergence of plasmid mediated AmpC β-lactamasas: Origin, importance, detection and therapeutical options. Rev. Esp. Quimioter. Publ. Of. Soc. Esp. Quimioter. 2012, 25, 89–99. [Google Scholar]
- Calvo, J.; Cantón, R.; Fernández Cuenca, F.; Mirelis, B.; Navarro, F. Detección fenotípica de mecanismos de resistencia en gramnegativos. Soc. Española De Enferm. Infecc. y Microbiol. Clin. 2011, 7, 524–534. [Google Scholar]
- Tamma, P.D.; Girdwood, S.C.; Gopaul, R.; Tekle, T.; Roberts, A.A.; Harris, A.D.; Cosgrove, S.E.; Carroll, K.C. The use of cefepime for treating AmpC β-lactamase-producing Enterobacteriaceae. Clin. Infect. Dis. 2013, 57, 781–788. [Google Scholar] [CrossRef]
- Philippon, A.; Arlet, G.; Jacoby, G.A. Plasmid-determined AmpC-type beta-lactamases. Antimicrob. Agents Chemother. 2002, 46, 1–11. [Google Scholar] [CrossRef] [PubMed]
- Pitout, J.D.; Gregson, D.B.; Church, D.L.; Laupland, K.B. Population-based laboratory surveillance for AmpC beta-lactamase-producing Escherichia coli, Calgary. Emerg. Infect. Dis. 2007, 13, 443–448. [Google Scholar] [CrossRef] [PubMed]
- EUCAST Guidelines for Detection of Resistance Mechanisms and Specific Resistances of Clinical and/or Epidemiological Importance. 2007. Available online: https://www.eucast.org/fileadmin/src/media/PDFs/EUCAST_files/Resistance_mechaaisms/EUCAST_detection_of_resistance_mechanisms_170711.pdf (accessed on 1 July 2022).
- Ingram, P.R.; Inglis, T.J.J.; Vanzetti, T.R.; Henderson, B.A.; Harnett, G.B.; Murray, R.J. Comparison of methods for AmpC β-lactamase detection in Enterobacteriaceae. J. Med. Microbiol. 2011, 60, 715–721. [Google Scholar] [CrossRef] [PubMed]
- Silva-Dias, A.; Pérez-Viso, B.; Martins-Oliveira, I.; Gomes, R.; Rodrigues, A.G.; Cantón, R.; Pina-Vaz, C. Evaluation of FASTinov ultrarapid flow cytometry antimicrobial susceptibility testing directly from positive blood cultures. J. Clin. Microbiol. 2021, 59, e0054421. [Google Scholar] [CrossRef]
- Faria-Ramos, I.; Espinar, M.J.; Rocha, R.; Santos-Antunes, J.; Rodrigues, A.G.; Cantón, R.; Pina-Vaz, C. A novel flow cytometric assay for rapid detection of extended-spectrum beta-lactamases. Clin. Microbiol. Infect. 2013, 19, E8–E15. [Google Scholar] [CrossRef] [PubMed]
- Silva, A.P.; Faria-Ramos, I.; Ricardo, E.; Miranda, I.M.; Espinar, M.J.; Costa-de-Oliveira, S.; Cantón, R.; Rodrigues, A.G.; Pina-Vaz, C. Rapid Flow Cytometry Test for Identification of Different Carbapenemases in Enterobacteriaceae. Antimicrob. Agents Chemother. 2016, 60, 3824–3826. [Google Scholar] [CrossRef]
- Ribeiro, T.G.; Novais, Â.; Rodrigues, C.; Nascimento, R.; Freitas, F.; Machado, E.; Peixe, L. Dynamics of clonal and plasmid backgrounds of Enterobacteriaceae producing acquired AmpC in Portuguese clinical settings over time. Int. J. Antimicrob. Agents 2019, 53, 650–656. [Google Scholar] [CrossRef]
- Bou, G.; Oliver, A.; Ojeda, M.; Monzón, C.; Martínez-Beltrán, J. Molecular characterization of FOX-4, a new AmpC-type plasmid-mediated beta-lactamase from an Escherichia coli strain isolated in Spain. Antimicrob. Agents Chemother. 2000, 44, 2549–2553. [Google Scholar] [CrossRef]
- Peter-Getzlaff, S.; Polsfuss, S.; Poledica, M.; Hombach, M.; Giger, J.; Böttger, E.C.; Zbinden, R.; Bloemberg, G.V. Detection of AmpC beta-lactamase in Escherichia coli: Comparison of three phenotypic confirmation assays and genetic analysis. J. Clin. Microbiol. 2011, 49, 2924–2932. [Google Scholar] [CrossRef]
- Correa-Martínez, C.L.; Idelevich, E.A.; Sparbier, K.; Kostrzewa, M.; Becker, K. Rapid Detection of Extended-Spectrum β-Lactamases (ESBL) and AmpC β-Lactamases in Enterobacterales: Development of a Screening Panel Using the MALDI-TOF MS-Based Direct-on-Target Microdroplet Growth Assay. Front. Microbiol. 2019, 10, 13. [Google Scholar] [CrossRef]
- Danhof, M.; Klein, K.; Stolk, P.; Aitken, M.; Leufkens, H. The future of drug development: The paradigm shift towards systems therapeutics. Drug Discov. Today 2018, 23, 1990–1995. [Google Scholar] [CrossRef] [PubMed]
- Li, C.; Ding, S.; Huang, Y.; Wang, Z.; Shen, J.; Ling, H.; Xu, Y. Detection of AmpC β-lactamase-producing Gram-negative bacteria by matrix-assisted laser desorption/ionization time-of-flight mass spectrometry. J. Hosp. Infect. 2018, 99, 200–207. [Google Scholar] [CrossRef] [PubMed]
- Andrade, F.F.; Gomes, R.; Martins-Oliveira, I.; Dias, A.; Rodrigues, A.G.; Pina-Vaz, C. A Rapid Flow Cytometric Antimicrobial Susceptibility Assay (FASTvet) for Veterinary Use—Preliminary Data. Front. Microbiol. 2020, 11, 1944. [Google Scholar] [CrossRef] [PubMed]
- Nadjar, D.; Rouveau, M.; Verdet, C.; Donay, J.-L.; Herrmann, J.-L.; Lagrange, P.H.; Philippon, A.; Arlet, G. Outbreak of Klebsiella pneumoniae producing transferable AmpC-type β-lactamase (ACC-1) originating from Hafnia alvei. FEMS Microbiol. Lett. 2000, 187, 35–40. [Google Scholar] [CrossRef]
- Pestourie, N.; Garnier, F.; Barraud, O.; Bedu, A.; Ploy, M.C.; Mounier, M. Outbreak of AmpC β-lactamase-hyper-producing Enterobacter cloacae in a neonatal intensive care unit in a French teaching hospital. Am. J. Infect. Control. 2014, 42, 456–458. [Google Scholar] [CrossRef] [PubMed]
- Hernández-García, M.; García-Fernández, S.; García-Castillo, M.; Bou, G.; Cercenado, E.; Delgado-Valverde, M.; Mulet, X.; Pitart, C.; Rodríguez-Lozano, J.; Tormo, N.; et al. WGS characterization of MDR Enterobacterales with different ceftolozane/tazobactam susceptibility profiles during the SUPERIOR surveillance study in Spain. J. Antimicrob. Resist. 2020, 2, dlaa084. [Google Scholar] [CrossRef] [PubMed]
- Pérez-Pérez, F.J.; Hanson, N.D. Detection of plasmid-mediated AmpC beta-lactamase genes in clinical isolates by using multiplex PCR. J. Clin. Microbiol. 2002, 40, 2153–2162. [Google Scholar] [CrossRef] [PubMed]
- ISO 20776-2:2021; Clinical Laboratory Testing and in vitro Diagnostic Test Systems—Susceptibility Testing of Infectious Agents and Evaluation of Performance of Antimicrobial Susceptibility Test Devices—Part 2: Evaluation of Performance of Antimicrobial Susceptibility Test Devices against Reference Broth Micro-dilution. Available online: https://www.iso.org/standard/79377.html (accessed on 1 July 2022).

Publisher’s Note: MDPI stays neutral with regard to jurisdictional claims in published maps and institutional affiliations. |
© 2022 by the authors. Licensee MDPI, Basel, Switzerland. This article is an open access article distributed under the terms and conditions of the Creative Commons Attribution (CC BY) license (https://creativecommons.org/licenses/by/4.0/).
Share and Cite
Martins-Oliveira, I.; Pérez-Viso, B.; Silva-Dias, A.; Gomes, R.; Peixe, L.; Novais, Â.; Cantón, R.; Pina-Vaz, C. Rapid Detection of Plasmid AmpC Beta-Lactamases by a Flow Cytometry Assay. Antibiotics 2022, 11, 1130. https://doi.org/10.3390/antibiotics11081130
Martins-Oliveira I, Pérez-Viso B, Silva-Dias A, Gomes R, Peixe L, Novais Â, Cantón R, Pina-Vaz C. Rapid Detection of Plasmid AmpC Beta-Lactamases by a Flow Cytometry Assay. Antibiotics. 2022; 11(8):1130. https://doi.org/10.3390/antibiotics11081130
Chicago/Turabian StyleMartins-Oliveira, Inês, Blanca Pérez-Viso, Ana Silva-Dias, Rosário Gomes, Luísa Peixe, Ângela Novais, Rafael Cantón, and Cidália Pina-Vaz. 2022. "Rapid Detection of Plasmid AmpC Beta-Lactamases by a Flow Cytometry Assay" Antibiotics 11, no. 8: 1130. https://doi.org/10.3390/antibiotics11081130
APA StyleMartins-Oliveira, I., Pérez-Viso, B., Silva-Dias, A., Gomes, R., Peixe, L., Novais, Â., Cantón, R., & Pina-Vaz, C. (2022). Rapid Detection of Plasmid AmpC Beta-Lactamases by a Flow Cytometry Assay. Antibiotics, 11(8), 1130. https://doi.org/10.3390/antibiotics11081130

